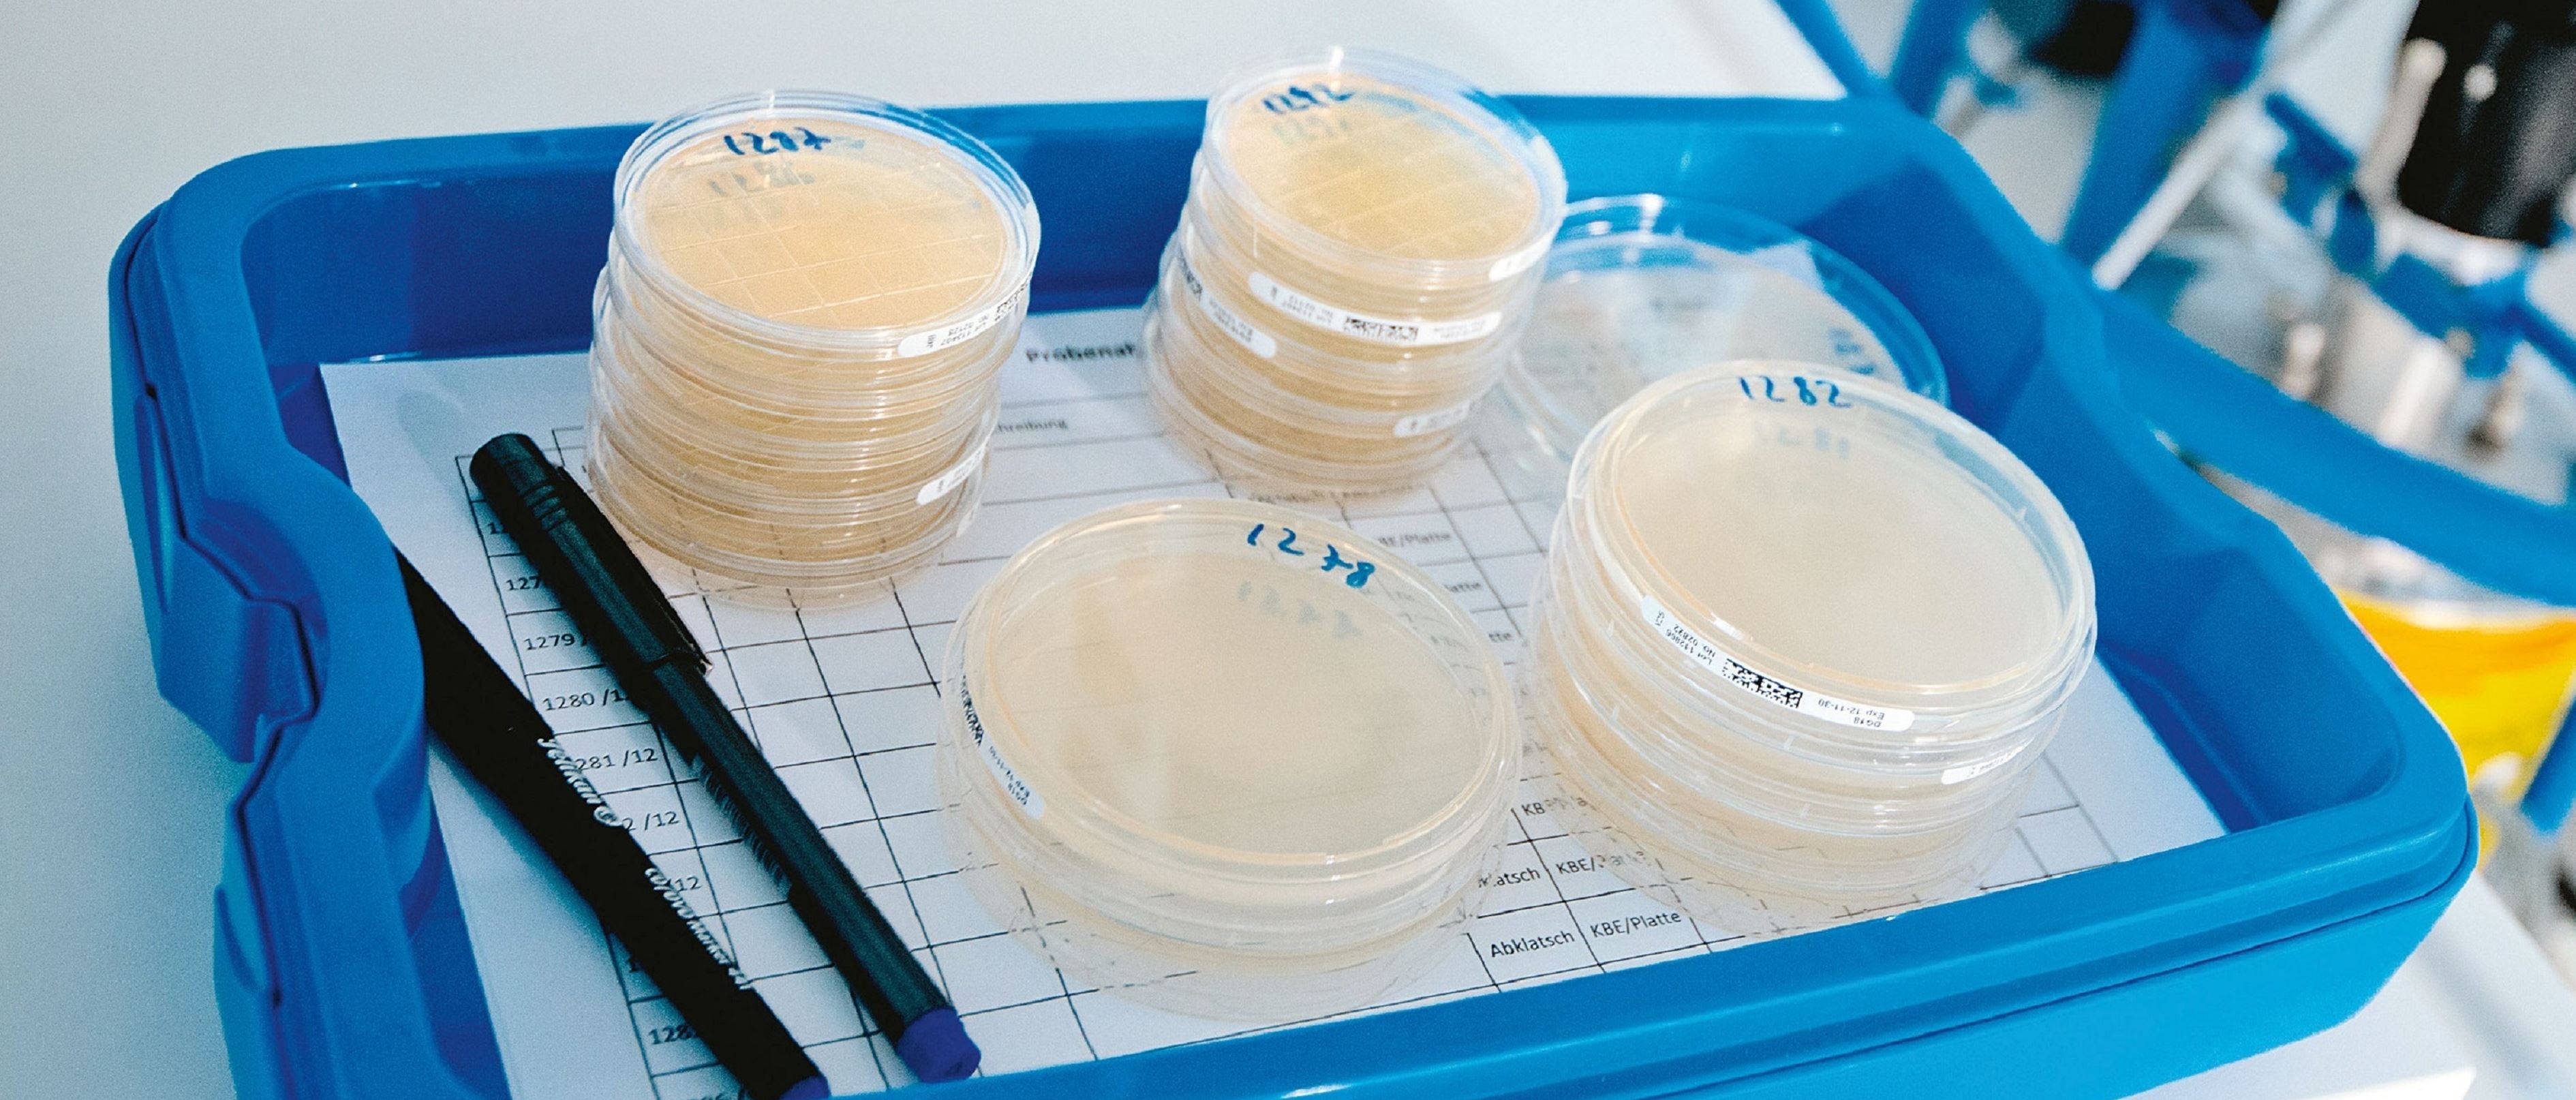
Keimidentifikation und mikrobiologisches Gutachten.jpg Keimidentifikation und mikrobiologisches Gutachten.jpg
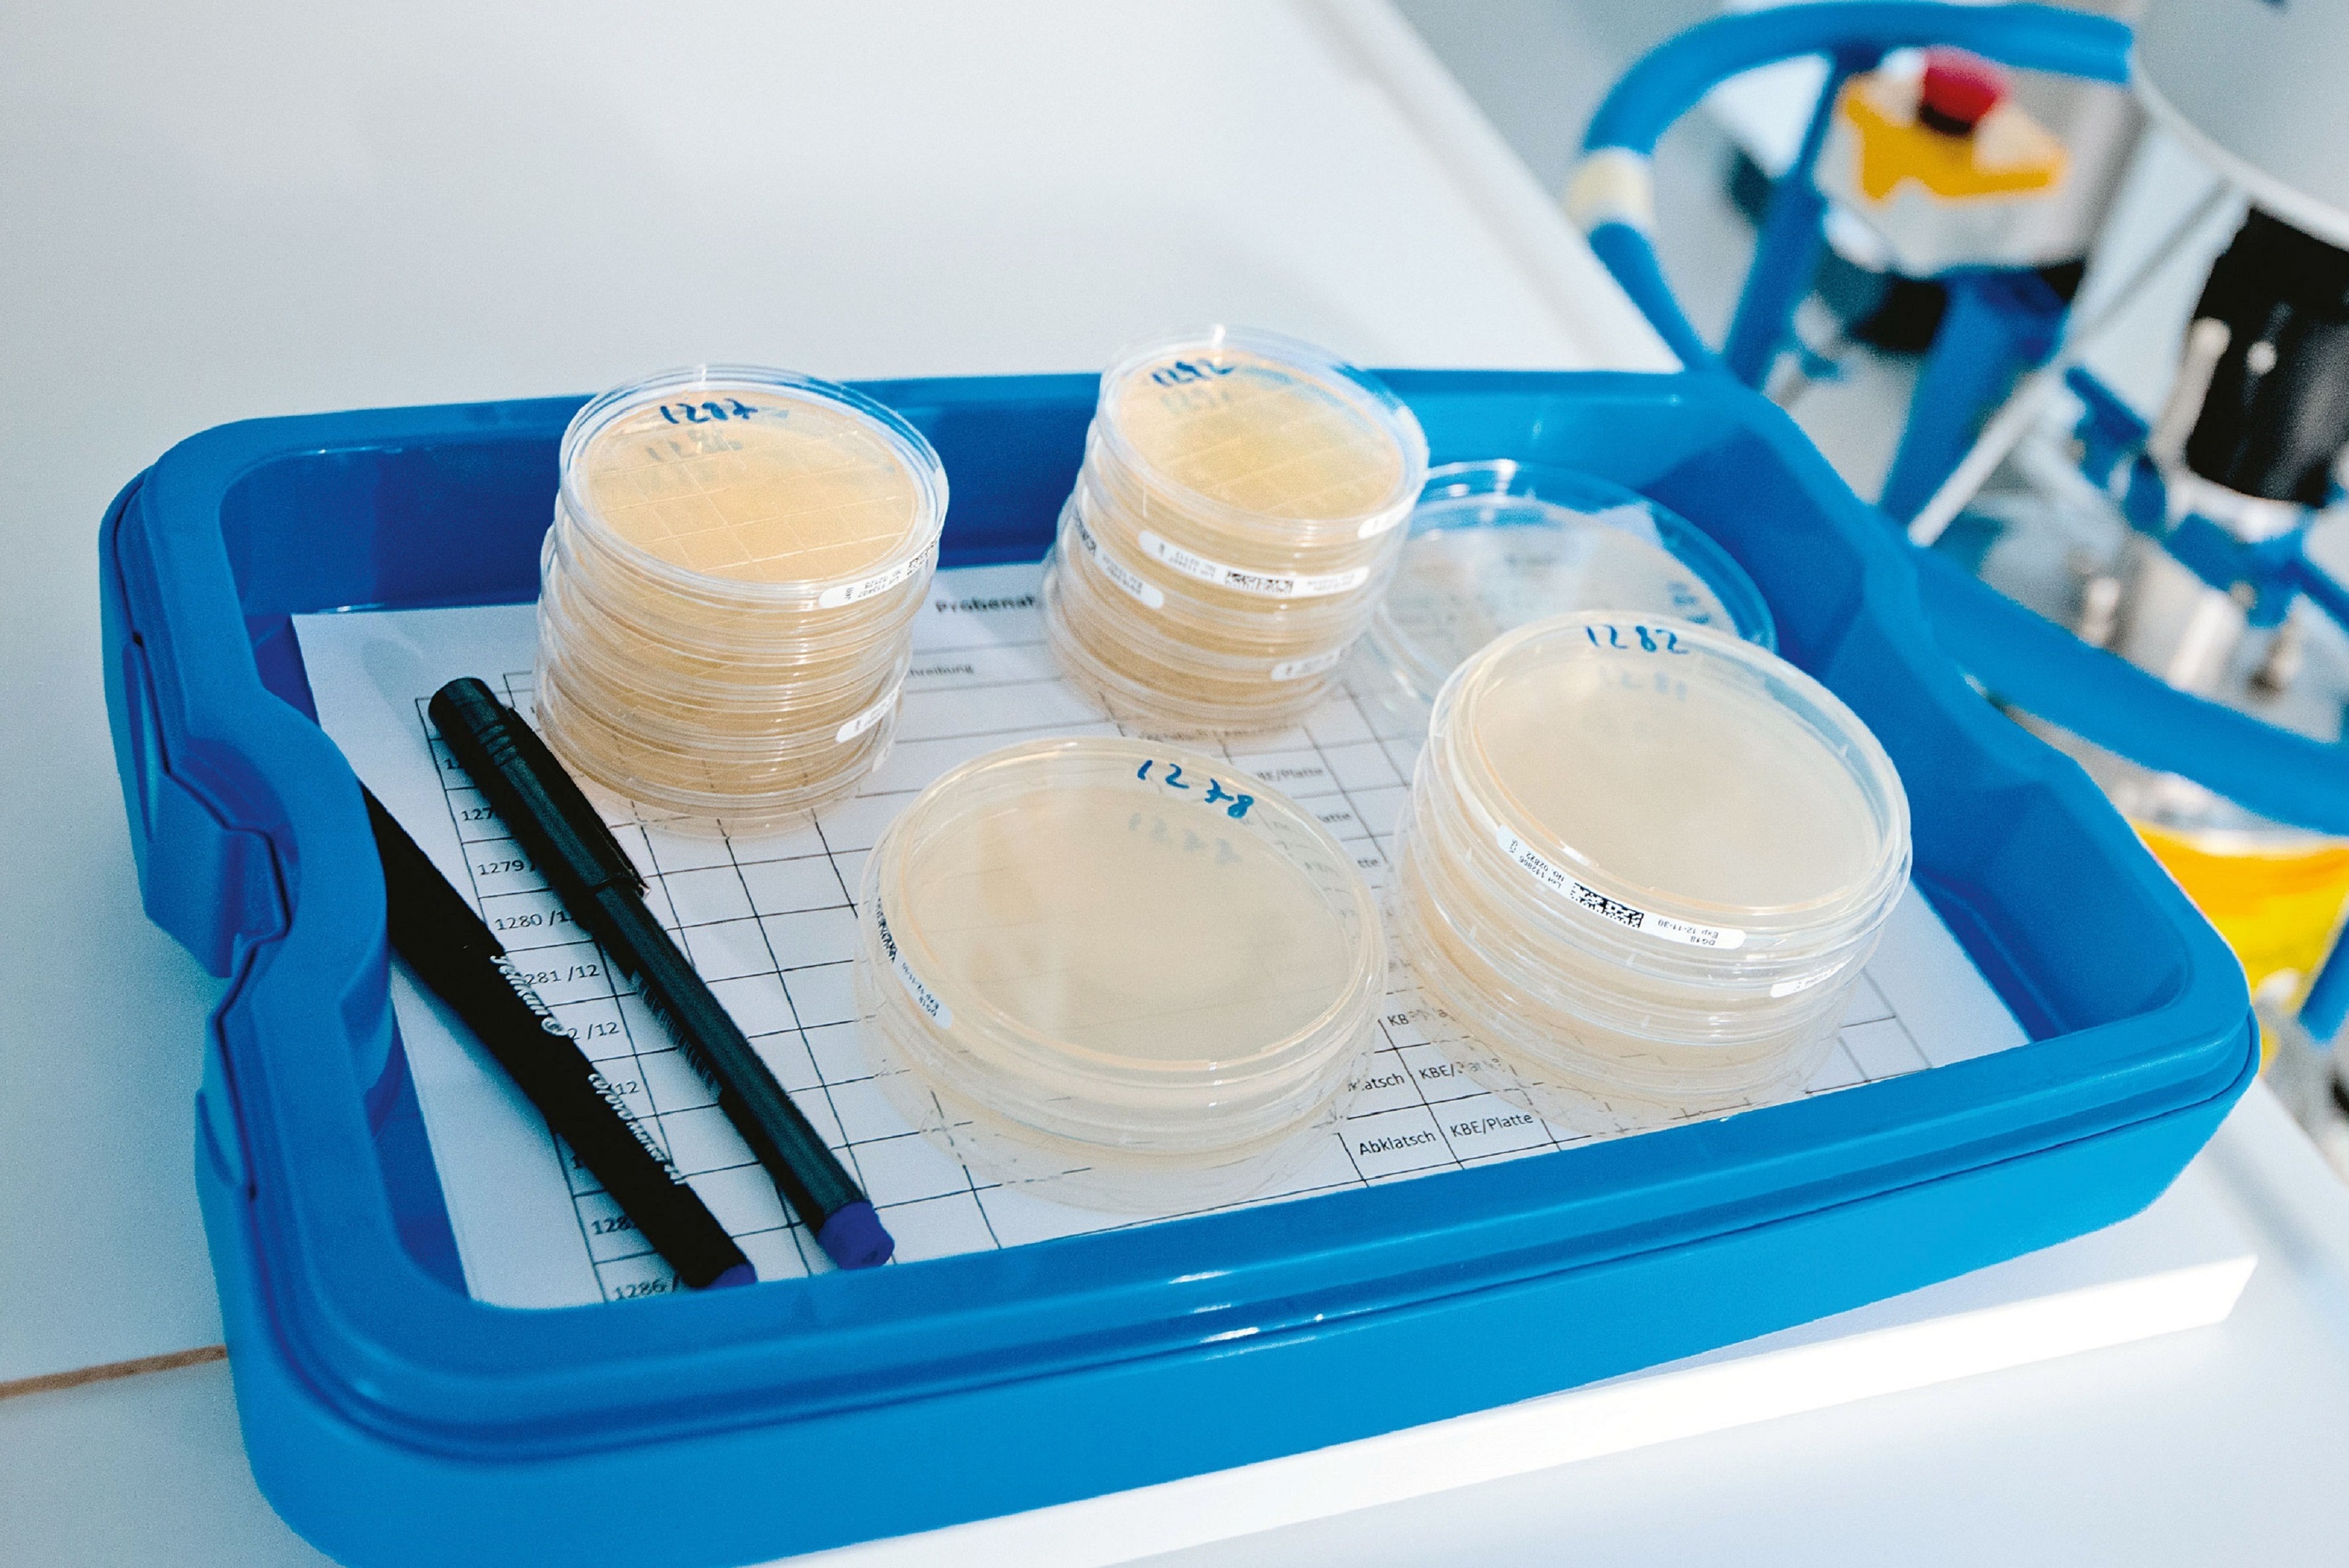
Keimidentifikation und mikrobiologisches Gutachten.jpg

Von der Pharma- und Biotech-Industrie bis zum OP-Saal – die Luftqualität spielt im Reinraum-Bereich und in Bereichen mit hohen hygienischen Ansprüchen eine wesentliche Rolle. Wir sorgen dafür, dass die Qualität der Luft den vorgegebenen Normen und Richtlinien entspricht.